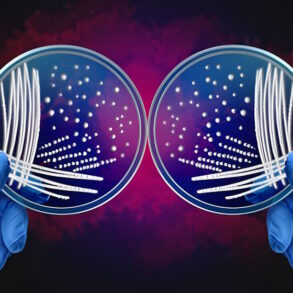
Зеркальные клетки и зеркальные бактерии

Возьмем в качестве примера ваши руки. Они, по сути, идентичны во всех отношениях, кроме одного: они являются зеркальными отражениями друг друга. Многие молекулы жизни, такие как белки и ДНК, обладают...
Зеркальные нейроны (зеркальные клетки мозга) Зеркальные нейроны — это специализированные нервные...
Сектор здравоохранения находится на раннем этапе крупной революции, связанной с...
Учёные-биоинженеры из Университета Миннесоты разработали искусственные кровеносные сосуды, которые после...
Исследователями из Медицинской школы Калифорнийского университета в Сан-Диего и Бостонского...
Лазерная эпиляция голени — один из самых эффективных методов удаления...
Лазерная эпиляция стала золотым стандартом в области долговременного удаления нежелательных...
Шея – одна из зон, которая предательски выдает возраст. Кожа...
В офтальмологии таурин занимает особое место, будучи признанным одним из...
Современная эстетическая и рефракционная хирургия предлагает пациентам комплексные решения для...
Контактные линзы, использующиеся для коррекции зрения, условно делят на мягкие...

Записаться к врачу
Запишитесь на прием к врачу через нашу электронную регистратуру. Доступна большая база специалистов всех направлений в вашем городе
Хирургия
Разрушение коленных хрящевых тканей может происходить в силу разных причин. В пожилом возрасте это обуславливается...
Стоматология
❓ 1. Что такое диастема? Ответ стоматолога: Диастема — это неприродный промежуток (щель) между двумя зубами, чаще...
Терапия
Избыточный рост волос на теле — проблема, которая беспокоит многих людей, но...
Стереотип о том, что суставы — проблема пожилых, опасно устарел. Ноющая боль...
Анонимная наркологическая помощь в «Урал Медикал Групп»
Гарантия полной конфиденциальности